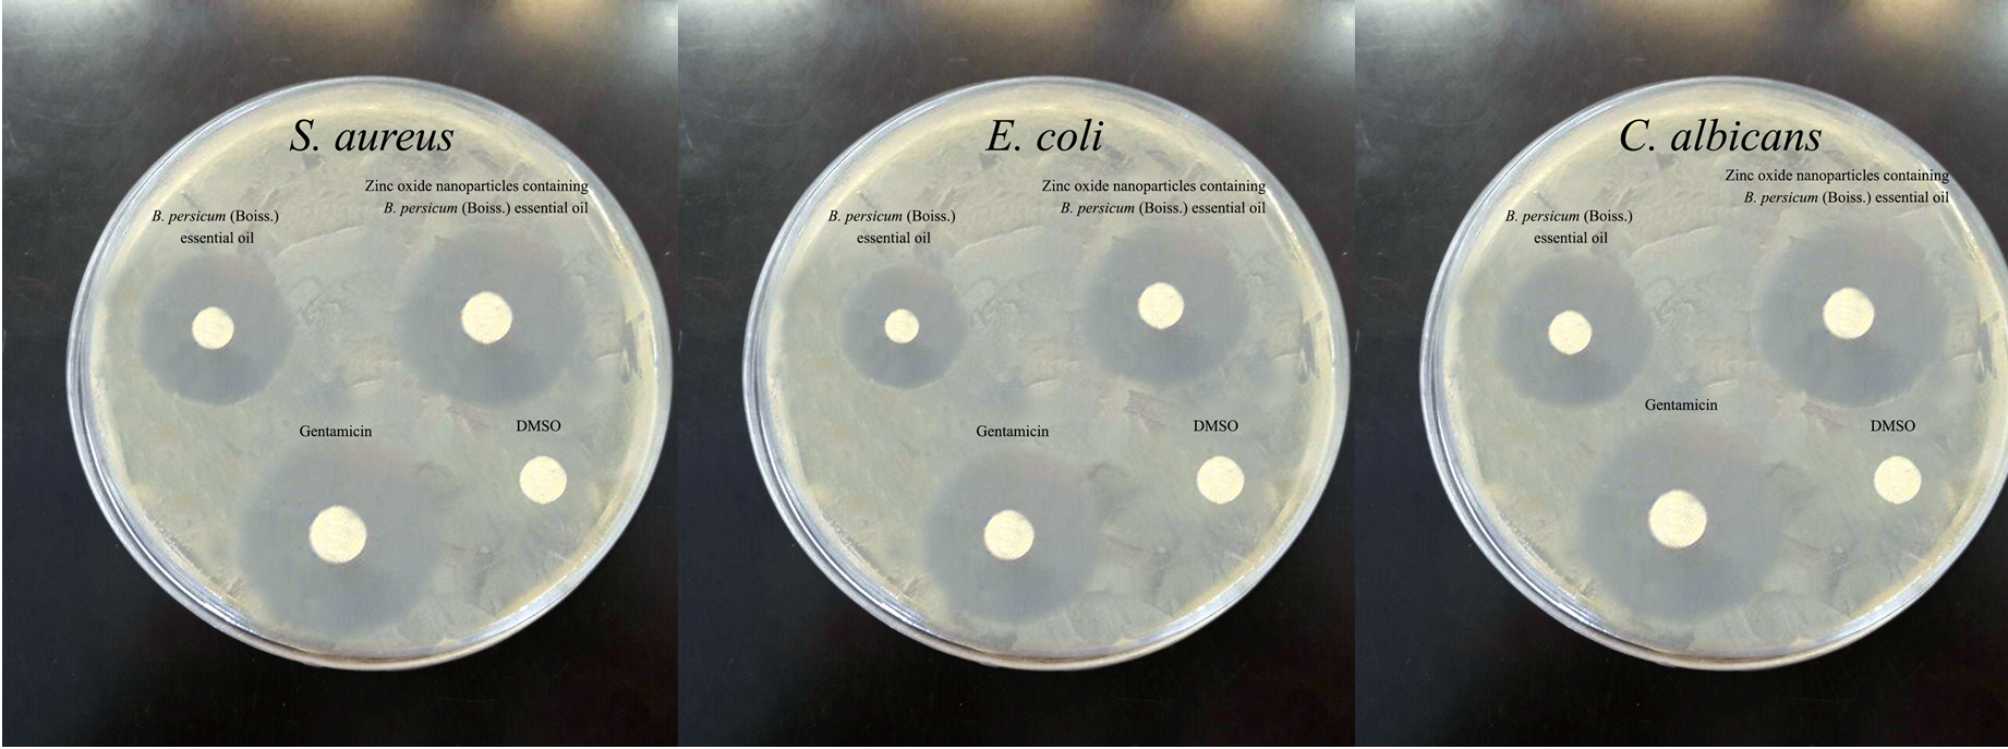
Fig. 3

Fig. 3

Antimicrobial effects of nanoparticles containing B. persicum (Boiss.) B. Fedtsch. essential oil in some antibiotics using disk diffusion method.
Antimicrobial effects of nanoparticles containing B. persicum (Boiss.) B. Fedtsch. essential oil in some antibiotics using disk diffusion method.